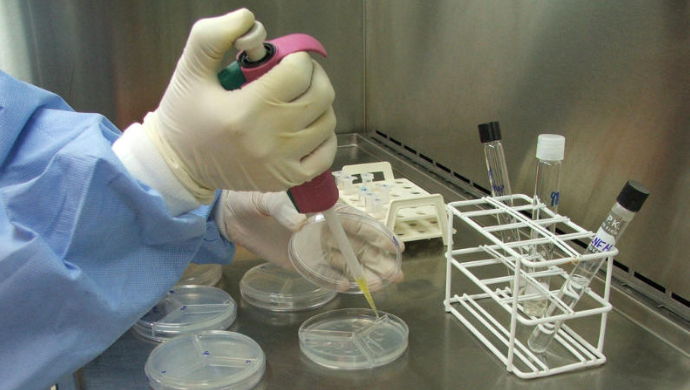

Copyrights © Habbonight 2010 ~ 2026
Todos direitos reservados à HabboNight. Plágio é crime.
Esta Fã Site não está afiliada com, patrocinada por, apoiada por, ou principalmente aprovada pela Sulake Oy ou suas empresas Afiliadas. Esta Fã Site pode utilizar as marcas registradas e outras propriedades intelectuais do Habbo, que estão permitidas sob a Política de Fã Sites Habbo.
Layout desenvolvido por @Mozart (Amadeus Portugal),
Janjao.ban (Jorge) e MarcioPG.BAN (Márcio Palheta).